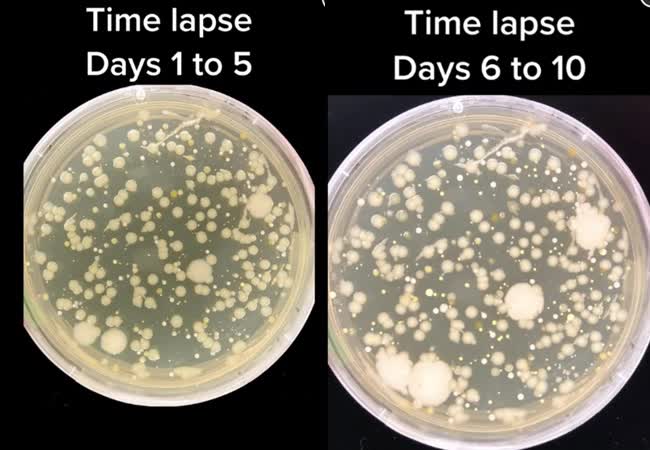
Ai cũng d&ugrave;ng vật n&agrave;y để rửa rau, thực phẩm nhưng kh&ocirc;ng hề biết c&ograve;n bẩn hơn bồn cầu, bệnh truyền nhiễm từ đ&acirc;y m&agrave; ra - Ảnh 2.

Ai cũng dùng vật này để rửa rau, thực phẩm nhưng không hề biết còn bẩn hơn bồn cầu, bệnh truyền nhiễm từ đây mà ra
Thói quen rửa thực phẩm trong bồn rửa bát tưởng chừng rất bình thường mà ngày nào các chị cũng làm tiềm ẩn hiểm họa khôn lường gây hại cho sức khỏe.
Ổ vi khuẩn đáng sợ ở bồn rửa bát
Khi nhắc đến nơi bẩn nhất trong nhà, nhiều người sẽ nghĩ ngay đến bồn cầu nhưng thực chất bồn rửa nhà bếp mới là thứ "bẩn" và tiềm ẩn nhiều nguy cơ lan truyền vi khuẩn nhất.
Tiến sĩ Charles Gerba, nhà vi trùng học và giáo sư tại Đại học Arizona (Mỹ) cho biết: "Bồn rửa nhà bếp là nơi chứa đầy vi trùng bởi bạn đổ mọi thứ vào nó. Bạn thái thịt sống sau đó rửa sạch thớt trong bồn rửa. Bạn đổ đồ ăn thừa vào bồn rửa. Bạn rã đông các loại thịt đông lạnh hoặc rửa gà sống. Đó là lý do vì sao có nhiều vi khuẩn trong bồn rửa hơn cả trong bồn cầu".

Rửa rau, thực phẩm sống trong bồn rửa bát là thói quen của nhiều chị em phụ nữ
Ngoài thực phẩm, thì miếng giẻ rửa bát cũng có thể là nguyên nhân gây nhiễm khuẩn cho bồn rửa. Vị tiến sĩ nói, có đến 10 triệu vi khuẩn trên mỗi inch vuông (1 inch="2",54cm) của miếng giẻ bằng mút, và khoảng một triệu con nếu miếng giẻ bằng vải. Thậm chí, miếng giẻ rửa bát còn bẩn gấp 200.000 lần bồn cầu.
Trong bồn rửa, có thể chứa các vi khuẩn gây bệnh truyền qua thực phẩm, phổ biến nhất là Campylobacter jejuni, Salmonella và Escherichia coli. Trong đó, E.coli là nguyên nhân gây tiêu chảy, viêm phổi, đồng thời là thủ phạm của 80% các trường hợp viêm đường tiết niệu.
Làm thế nào để rửa sạch bồn rửa bát
Để làm sạch bồn rửa của gia đình, hầu hết chúng ta đều cọ sạch với xà phòng, sau đó rửa lại bằng nước nóng. Tuy nhiên, trong một video đang "gây bão" trên mạng xã hội Tiktok của tài khoản có tên What Might Grow đã chứng minh tất cả các phương pháp này đều vô dụng.
Theo đó, tác giả đã thử nghiệm cho đồ ăn vào bồn rửa, sau đó rửa sạch bằng nước thường. Sau khi lấy mẫu nước trong bồn và soi dưới kính hiển vi, người này phát hiện một số lượng vi khuẩn rất lớn.
Ở cách thứ hai, tác giả đã đổ xà phòng vào bồn rửa rồi tiến hành kỳ cọ thật kỹ trong vòng 1 phút, cuối cùng dùng nước nóng rửa sạch xà phòng. Tiếp đó, tác giả lấy mẫu nước trong bồn để đem soi dưới kính hiển vi.
Ước tính chỉ từ 20 đã sinh sôi lên đến số lượng 45.000 con vi khuẩn trong vòng 10 ngày - Ảnh cắt từ clip
Kết quả cho thấy rằng những ngày đầu tiên phần nước này rất sạch sẽ, không có dấu hiệu của vi khuẩn. Tuy nhiên sau đó, vi khuẩn bắt đầu xuất hiện, sinh sôi rất nhanh. Ước tính chỉ từ 20 đã sinh sôi lên đến số lượng 45.000 con vi khuẩn trong vòng 10 ngày. Cuối video, tác giả nhận định bồn rửa dù cho đã sử dụng nước nóng và xà phòng thì cũng chưa thể sạch được hoàn toàn.
Vậy quy trình khử khuẩn bồn rửa phải làm sao mới đúng?
Trước khi làm sạch bồn, bạn cần phải dọn dẹp toàn bộ đồ trong đó. Đừng để các vật dụng như nồi niêu, xoong chảo... trong bồn. Nên rửa bát đũa ngay hoặc cho chúng vào máy rửa bát ngay sau khi dọn bàn ăn.
Sử dụng chất tẩy rửa
Để vệ sinh chậu rửa chén một cách nhanh chóng và hiệu quả thì sử dụng các chất tẩy rửa như nước rửa chén hay các dung dịch tẩy rửa vệ sinh nhà bếp chuyên dụng là một trong những phương pháp không thể bỏ qua.
Nước nóng
Việc bồn rửa dù đã cọ bằng xà phòng hay nước nóng mà vẫn còn vi khuẩn là hoàn toàn có thể xảy ra. Bởi để tiêu diệt vi khuẩn chúng ta phải dùng nước 100 độ C, trong khi đó nước nóng ở vòi chưa đủ nóng đến mức đó. Do đó, hãy tự đun sôi nước rồi đổ trực tiếp vào những vùng bám bẩn nhiều trên chậu rửa chén.
Bạn đợi trong khoảng 2 - 3 phút cho các vết bẩn tách khỏi bề mặt, sau đó dùng bàn chải hoặc miếng rửa chén chà rửa với một ít xà phòng rửa chén rồi xả sạch lại bằng nước lạnh là được.
Dùng baking soda và giấm
Bạn sẽ cần baking soda, chanh, giấm không pha loãng và dầu ô liu. Sau khi dọn sạch và làm rửa sạch bồn, bạn rắc baking soda lên bề mặt bồn thành một lớp mỏng, sau đó dùng bọt biển mềm, vải để chà nhẹ nhàng bề mặt bồn. Sau đó, bạn cắt đôi quả chanh, vắt vào hỗn hợp muối đó, rồi dùng nửa còn lại chà bồn. Cuối cùng, bạn xả sạch bồn, lau khô và nhỏ một vài giọt oliu vào khăn giấy để làm sạch bồn hoàn toàn.
Chanh tươi và phèn chua
Chanh tươi và phèn chua từ lâu đã được biết đến là những nguyên liệu có hiệu quả tẩy rửa cao. Chính bởi vậy, việc sử dụng kết hợp chanh tươi và phèn chua để vệ sinh sẽ đem lại cho bạn chiếc chậu rửa chén sạch bong, sáng bóng.
Cách thực hiện rất đơn giản, hòa tan hỗn hợp nước cốt chanh và phèn chua theo tỷ lệ 1:1. Tiếp đến, nhúng miếng rửa chén hoặc khăn lau vào hỗn hợp rồi lau khắp bề mặt chậu rửa chén rồi rửa sạch lại với nước. Đối với những vùng có nhiều vết bẩn hoặc vết bẩn dày, bạn nên đổ trực tiếp hỗn hợp lên bề mặt và đợi trong khoảng 20 - 30 phút trước khi rửa lại với nước để hiệu quả được tốt hơn.

Rửa sạch bồn rửa bát mỗi ngày để ngăn chặn vi khuẩn phát triển
Hỗn hợp muối và chanh
Nếu không có phèn chua thì bạn có thể thay bằng muối. Cụ thể, rắc một lượng muối hạt vừa đủ lên chậu rửa chén, đợi trong vòng khoảng 2 - 3 phút, sau đó dùng miếng rửa chén hoặc bàn chải chà muối lên khắp bề mặt chậu.
Tiếp đến, cắt đôi quả chanh rồi đem chà tiếp lên trên bề mặt chậu rửa chén để loại bỏ hoàn toàn các vết bẩn và khử mùi cho chậu. Sau khi đã chà sạch các vết bẩn, bạn dọn vỏ chanh và xả lại chậu rửa chén bằng nước là được.
Kết hợp muối, giấm và nước ấm
Muối, giấm và nước ấm là 3 nguyên liệu có công năng tẩy rửa và khử mùi hiệu quả, lại dễ kiếm nên thường xuyên được các bà nội trợ sử dụng trong việc vệ sinh các vật dụng nhà bếp.
Việc sử dụng kết hợp cùng lúc cả 3 nguyên liệu này sẽ giúp bạn làm sạch và khử mùi chậu rửa chén nhanh chóng nhờ vào tính tẩy rửa, khử mùi của giấm, tính mài mòn, khử khuẩn của muối, thêm vào đó là độ nóng của nước cho các phân tử của vết bẩn nhanh chóng tan rã.
Cho một lượng muối thích hợp vào chậu rửa chén, sau đó dùng miếng rửa chén hoặc bàn chải chà thật kỹ lên toàn bộ bề mặt của chậu. Tiếp đến, đổ đều giấm lên bề mặt chậu rửa chén, đặc biệt ở những vùng bám bẩn nhiều rồi tiếp tục chà sạch bề mặt chậu bằng miếng rửa chén hoặc bàn chải. Sau khi đã đánh bay hết các vết bẩn thì dùng nước ấm rửa sạch lại toàn bộ chậu rửa chén là được.
